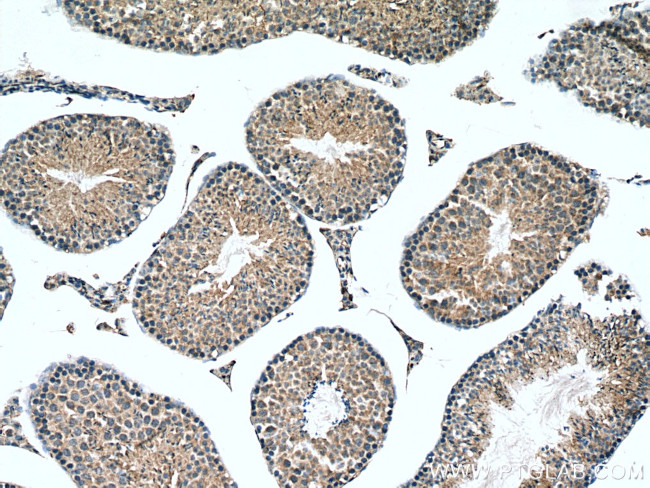
PLEKHO1 Antibody in Immunohistochemistry (Paraffin) (IHC (P))

Search
Proteintech
PLEKHO1 Polyclonal Antibody
{{$productOrderCtrl.translations['antibody.pdp.commerceCard.promotion.promotions']}}
{{$productOrderCtrl.translations['antibody.pdp.commerceCard.promotion.viewpromo']}}
{{$productOrderCtrl.translations['antibody.pdp.commerceCard.promotion.promocode']}}: {{promo.promoCode}} {{promo.promoTitle}} {{promo.promoDescription}}. {{$productOrderCtrl.translations['antibody.pdp.commerceCard.promotion.learnmore']}}
产品信息
24883-1-AP
种属反应
已发表种属
宿主/亚型
分类
类型
抗原
偶联物
形式
浓度
规格
纯化类型
保存液
内含物
保存条件
运输条件
产品详细信息
Immunogen sequence: VASTSTSDG MLTLDLIQEE DPSPEEPTSC AESFRVDLDK SVAQLAGSRR RADSDRIQPS ADRASSLSRP WEKTDKGATY TPQAPKKLTP TEKGRCASLE EILSQRDAAS ARTLQLRAEE PPTPALPNPG QLSRIQDLVA RKLEETQELL AEVQGLGDGK RKAKDPPRSP PDSESEQLLL ETERLLGEAS SNWSQAKRVL QEVRELRDLY RQMDLQTPDS HLRQTTPHSQ YRKSLM (175-409 aa encoded by BC010149)
靶标信息
CKIP1 was identified through a yeast-two hybrid screening as a protein that would interact with only one of the two catalytic subunits of the casein kinase 2 complex. CKIP1 is a pleckstrin homology domain-containing protein localized within the nucleus and at the plasma membrane that interacts with CK2alpha but not CK2alpha', and is thought to play a role in targeting CK2alpha to a particular cellular location. CKIP1 has been implicated in muscle differentiation and the regulation of cell morphology and actin cytoskeleton. CKIP1 can also interact with other proteins such as ATM, an upstream kinase of p53, and recruit the nuclear ATM to the plasma membrane, suggesting CKIP1 may regulate ATM function through re-localizing ATM. CKIP1 can also form a complex with the kinase AKT, leading to a down-regulation of PI3K/AKT signaling and suppression of tumor growth in vivo.
仅用于科研。不用于诊断过程。未经明确授权不得转售。
生物信息学
蛋白别名: C-Jun-binding protein; Casein kinase 2-interacting protein 1; CK2 interacting protein 1; CK2 interacting protein 1; HQ0024c protein; CK2-interacting protein 1; CKIP-1; pleckstrin-homology domain containing protein; HQ0024c protein; JBP; Jun zipper-associated 2; Osteoclast maturation-associated gene 120 protein; PH domain-containing family O member 1; Pleckstrin homology domain-containing family O member 1; RP11-458I7.3; similar to mouse c-Jun leucine zipper interactive; TNF intracellular domain-interacting protein; unnamed protein product
基因别名: 2810052M02Rik; CKIP-1; CKIP1; HQ0024c; JBP; JZA-20; Jza2; OC120; PLEKHO1
UniProt ID: (Human) Q53GL0, (Mouse) Q9JIY0
Entrez Gene ID: (Human) 51177, (Mouse) 67220